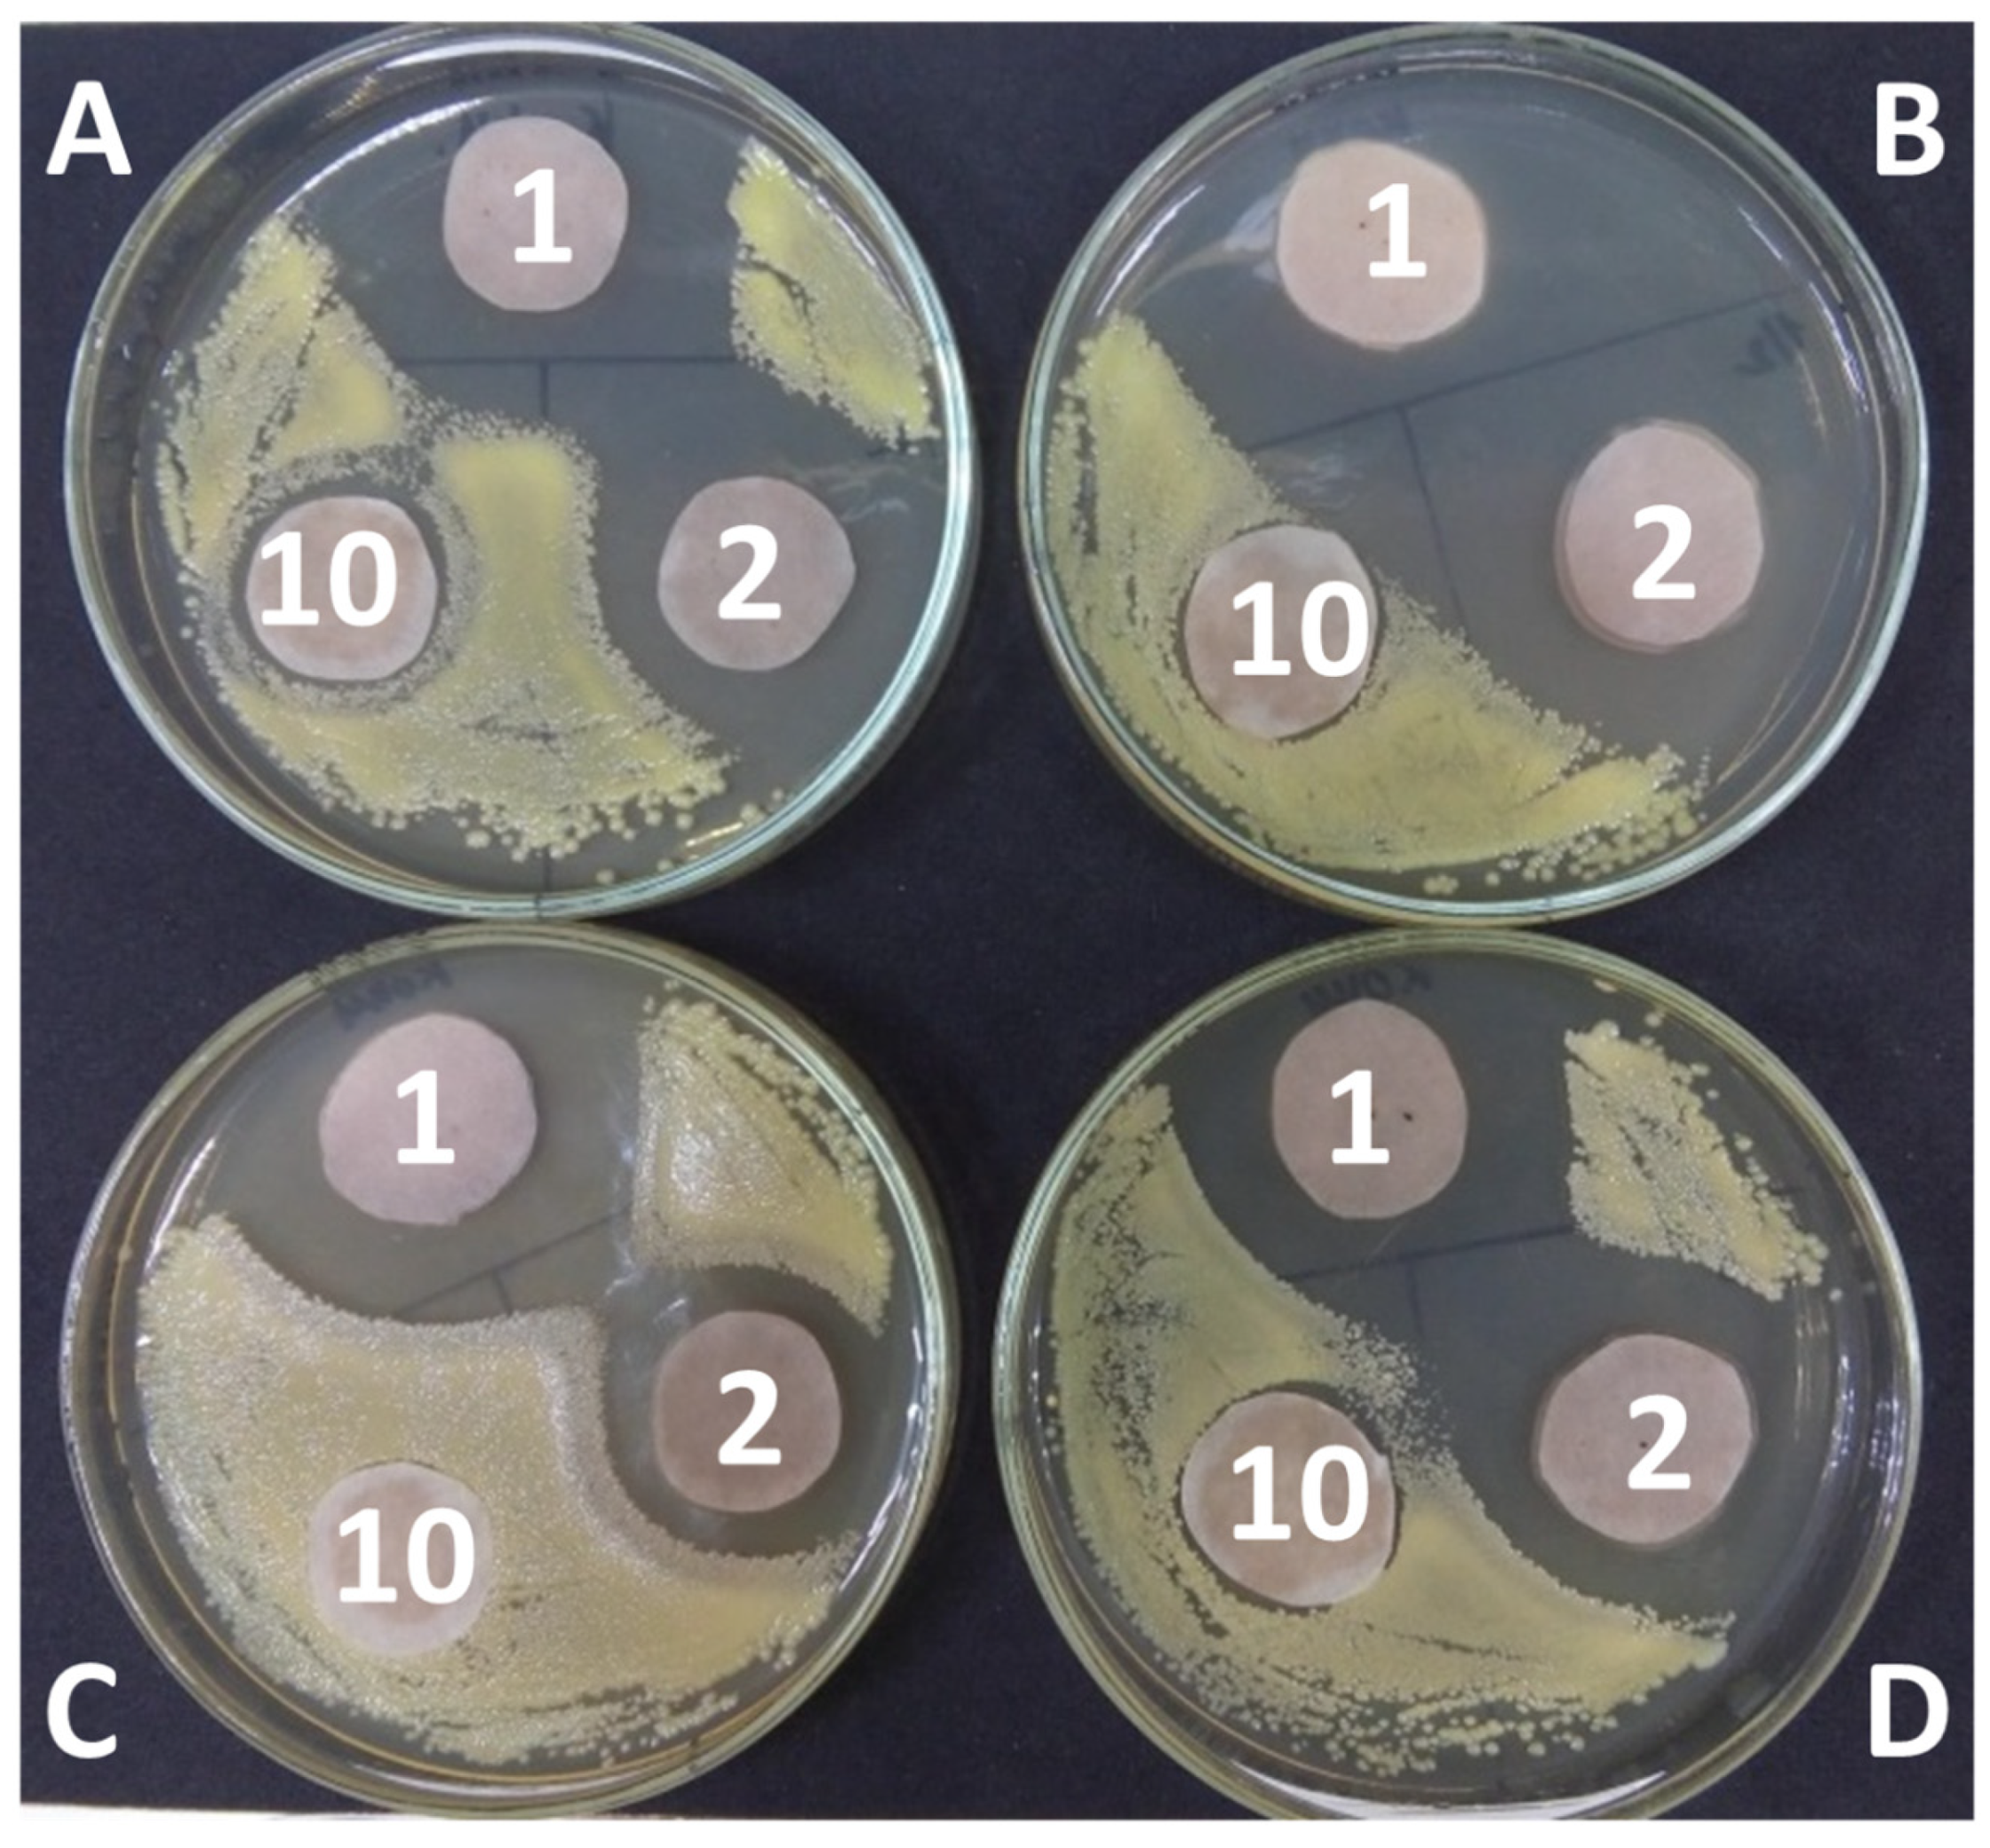
Molecules 28 00912 g008

Application of Natural Deep Eutectic Solvents for Extraction of Bioactive Components from Rhodiola rosea (L.)
Abstract
1. Introduction
2. Results and Discussion
3. Materials and Methods
3.1. Materials
3.2. Methods
3.2.1. Extraction
3.2.2. Chemical Analysis
3.2.3. In-Vitro Biological Activities Analysis
3.2.4. Analysis of Rosavin by HPLC
3.2.5. Antibacterial Activity
3.2.6. Statistical Analysis
4. Conclusions
Author Contributions
Funding
Institutional Review Board Statement
Data Availability Statement
Acknowledgments
Conflicts of Interest
References
- Panossian, A.; Wikman, G.; Sarris, J. Rosenroot (Rhodiola rosea): Traditional use, chemical composition, pharmacology and clinical efficacy. Phytomedicine 2010, 17, 481–493. [Google Scholar] [CrossRef] [PubMed]
- Kosakowska, O.; Bączek, K.; Przybył, J.L.; Pióro-Jabrucka, E.; Czupa, W.; Synowiec, A.; Gniewosz, M.; Costa, R.; Mondello, L.; Węglarz, Z. Antioxidant and Antibacterial Activity of Roseroot (Rhodiola rosea L.) Dry Extracts. Molecules 2018, 23, 1767. [Google Scholar] [CrossRef] [PubMed]
- Rohloff, J. Volatiles from rhizomes of Rhodiola rosea L. Phytochemistry 2002, 59, 655–661. [Google Scholar] [CrossRef]
- Zhuang, W.; Yue, L.; Dang, X.; Chen, F.; Gong, Y.; Lin, X.; Luo, Y. Rosenroot (Rhodiola): Potential Applications in Aging-related Diseases. Aging Dis. 2019, 10, 134. [Google Scholar] [CrossRef] [PubMed]
- Delépée, R.; Berteina-Raboin, S.; Lafosse, M.; Lamy, C.; Darnault, S.; Renimel, I.; About, N.; André, P. Synthesis, purification, and activity of salidroside. J. Liq. Chromatogr. Relat. Technol. 2007, 30, 2069–2080. [Google Scholar] [CrossRef]
- Ahmed, M.; Henson, D.A.; Sanderson, M.C.; Nieman, D.C.; Zubeldia, J.M.; Shanely, R.A. Rhodiola rosea Exerts Antiviral Activity in Athletes Following a Competitive Marathon Race. Front. Nutr. 2015, 2, 1–7. [Google Scholar] [CrossRef] [PubMed]
- Bany, J.; Zdanowska, D.; Skopińska-Rózewska, E.; Sommer, E.; Siwicki, A.K.; Wasiutyński, A. The effect of Rhodiola rosea extracts on the bacterial infection in mice. Cent. J. Immunol. 2009, 34, 35–37. [Google Scholar]
- Zhong, L.; Peng, L.; Fu, J.; Zou, L.; Zhao, G.; Zhao, J. Phytochemical, Antibacterial and Antioxidant Activity Evaluation of Rhodiola crenulata. Molecules 2020, 25, 3664. [Google Scholar] [CrossRef]
- Savina, T.A.; Myasikova, S.B.; Balakina, M.V. Optimization of conditions of cultivation for suspension culture of the Rhodiola rosea L. Vopr. Biol. Meditsinskoy Farmatsevticheskoy Khimii 2016, 19, 13–18. [Google Scholar]
- Kurkin, V.A. Phenylpropanoids from medicinal plants: Distribution, classification, structural analysis, and biological activity. Chem. Nat. Compd. 2003, 39, 123–153. [Google Scholar] [CrossRef]
- Ma, C.; Wang, H.; Gu, X.; Hu, L. Large-Scale Preparative Isolation of Rosavin from Rhodiola rosea via Ion Liquids MAE and Subsequent Flash Adsorption Chromatography. Sep. Sci. Technol. 2012, 47, 1821–1827. [Google Scholar] [CrossRef]
- Zhang, S.; Liu, C.; Bi, H.; Wang, C. Extraction of flavonoids from Rhodiola sachlinesis A. Bor by UPE and the antioxidant activity of its extract. Nat. Prod. Res. 2008, 22, 178–187. [Google Scholar] [CrossRef] [PubMed]
- Zhang, S.; Bi, H.; Liu, C. Extraction of bio-active components from Rhodiola sachalinensis under ultrahigh hydrostatic pressure. Sep. Purif. Technol. 2007, 57, 277–282. [Google Scholar] [CrossRef]
- Mao, Y.; Li, Y.; Yao, N. Simultaneous determination of salidroside and tyrosol in extracts of Rhodiola L. by microwave assisted extraction and high-performance liquid chromatography. J. Pharm. Biomed. Anal. 2007, 45, 510–515. [Google Scholar] [CrossRef] [PubMed]
- Fliniaux, O.; Corbin, C.; Ramsay, A.; Renouard, S.; Beejmohun, V.; Doussot, J.; Falguières, A.; Ferroud, C.; Lamblin, F.; Lainé, E.; et al. Microwave-assisted extraction of herbacetin diglucoside from flax (Linum usitatissimum L.) seed cakes and its quantification using an RP-HPLC-UV system. Molecules 2014, 19, 3025–3037. [Google Scholar] [CrossRef] [PubMed]
- Jin, T.; Liu, B.; You, M.-Y.; Wu, Y.-X.; Wang, Q. Supercritical Carbon Dioxide Extraction of Salidroside from Rhodiola rosea L var. rosea Root. J. Chin. Chem. Soc. 2011, 58, 222–227. [Google Scholar] [CrossRef]
- Abbott, A.P.; Capper, G.; Davies, D.L.; Rasheed, R.K.; Tambyrajah, V. Novel solvent properties of choline chloride/urea mixtures. Chem. Commun. 2003, 99, 70–71. [Google Scholar] [CrossRef]
- Choi, Y.H.; van Spronsen, J.; Dai, Y.; Verberne, M.; Hollmann, F.; Arends, I.W.C.E.; Witkamp, G.-J.J.; Verpoorte, R. Are Natural Deep Eutectic Solvents the Missing Link in Understanding Cellular Metabolism and Physiology? Plant Physiol. 2011, 156, 1701–1705. [Google Scholar] [CrossRef]
- Zainal-Abidin, M.H.; Hayyan, M.; Hayyan, A.; Jayakumar, N.S. New horizons in the extraction of bioactive compounds using deep eutectic solvents: A review. Anal. Chim. Acta 2017, 979, 1–23. [Google Scholar] [CrossRef]
- Tang, B.; Zhang, H.; Row, K.H. Application of deep eutectic solvents in the extraction and separation of target compounds from various samples. J. Sep. Sci. 2015, 38, 1053–1064. [Google Scholar] [CrossRef]
- Tsvetov, N.S.S.; Mryasova, K.P.P.; Shavarda, A.L.L.; Nikolaev, V.G.G. Estimation of extraction efficiency of salidroside from Rhodiola rosea using deep eutectic solvents. IOP Conf. Ser. Earth Environ. Sci. 2019, 315, 042002. [Google Scholar] [CrossRef]
- Tsvetov, N.S.; Mryasova, K.P.; Korotkova, G.V.; Asming, S.V.; Nikolaev, V.G. Extraction of cinnamic alcohol from Rhodiola rosea using deep eutectic solvents. IOP Conf. Ser. Earth Environ. Sci. 2019, 315, 042006. [Google Scholar] [CrossRef]
- Shikov, A.N.; Kosman, V.M.; Flissyuk, E.V.; Smekhova, I.E.; Elameen, A.; Pozharitskaya, O.N. Natural deep eutectic solvents for the extraction of phenyletanes and phenylpropanoids of Rhodiola rosea L. Molecules 2020, 25, 1826. [Google Scholar] [CrossRef] [PubMed]
- Tsvetov, N.; Sereda, L.; Korovkina, A.; Artemkina, N.; Kozerozhets, I.; Samarov, A. Ultrasound-assisted extraction of phytochemicals from Empetrum hermafroditum Hager. using acid-based deep eutectic solvent: Kinetics and optimization. Biomass Convers. Biorefinery 2022, 12, 145–156. [Google Scholar] [CrossRef]
- Tsvetov, N.; Pasichnik, E.; Korovkina, A.; Gosteva, A. Extraction of Bioactive Components from Chamaenerion angustifolium (L.) Scop. with Choline Chloride and Organic Acids Natural Deep Eutectic Solvents. Molecules 2022, 27, 4216. [Google Scholar] [CrossRef] [PubMed]

| Group 1 | Group 2 | TPC | TAC | DPPH | |||
|---|---|---|---|---|---|---|---|
| p-Value | Significance | p-Value | Significance | p-Value | Significance | ||
| Water | EtOH | <0.001 | Yes | <0.001 | Yes | 0.3 | No |
| Water | MA | <0.001 | Yes | <0.001 | Yes | <0.001 | Yes |
| Water | Mal | <0.001 | Yes | <0.001 | Yes | <0.001 | Yes |
| Water | Tar | <0.001 | Yes | <0.001 | Yes | 0.029 | Yes |
| Water | CA | <0.001 | Yes | <0.001 | Yes | <0.001 | Yes |
| EtOH | MA | <0.001 | Yes | <0.001 | Yes | <0.001 | Yes |
| EtOH | Mal | <0.001 | Yes | <0.001 | Yes | <0.001 | Yes |
| EtOH | Tar | <0.001 | Yes | <0.001 | Yes | 0.556 | No |
| EtOH | CA | 0.949 | No | <0.001 | Yes | <0.001 | Yes |
| MA | Mal | <0.001 | Yes | 1.000 | No | <0.001 | Yes |
| MA | Tar | 0.002 | Yes | <0.001 | Yes | <0.001 | Yes |
| MA | CA | <0.001 | Yes | 0.999 | No | <0.001 | Yes |
| Mal | Tar | <0.001 | Yes | <0.001 | Yes | 0.029 | Yes |
| Mal | CA | <0.001 | Yes | 0.999 | No | 0.076 | No |
| Tar | CA | <0.001 | Yes | <0.001 | Yes | <0.001 | Yes |
| Source | Sum of Squares | Mean Square | F-Value | p-Value | ||||||||||||
|---|---|---|---|---|---|---|---|---|---|---|---|---|---|---|---|---|
| RY | TPC | TAC | DPPH | RY | TPC | TAC | DPPH | RY | TPC | TAC | DPPH | RY | TPC | TAC | DPPH | |
| Model | 394,689.3 | 30,209.9 | 230.0 | 152.8 | 43,854.4 | 3356.7 | 25.6 | 17.0 | 4.94 | 4.09 | 1.93 | 6.41 | 0.023 | 0.038 | 0.198 | 0.011 |
| A-T | 3702.5 | 186.2 | 4.1 | 0.8 | 3702.5 | 186.2 | 4.1 | 0.8 | 0.42 | 0.23 | 0.31 | 0.32 | 0.539 | 0.648 | 0.597 | 0.590 |
| B-t | 107.1 | 4777.5 | 4.4 | 12.8 | 107.1 | 4777.5 | 4.4 | 12.8 | 0.01 | 5.83 | 0.33 | 4.81 | 0.916 | 0.047 | 0.584 | 0.064 |
| C-w | 312,504.7 | 270.3 | 2.2 | 1.5 | 312,504.7 | 270.3 | 2.2 | 1.5 | 35.21 | 0.33 | 0.17 | 0.58 | 0.001 | 0.584 | 0.695 | 0.472 |
| AB | 85.1 | 2337.7 | 2.4 | 22.1 | 85.1 | 2337.7 | 2.4 | 22.1 | 0.01 | 2.85 | 0.18 | 8.34 | 0.925 | 0.135 | 0.683 | 0.023 |
| AC | 415.2 | 18.9 | 15.2 | 10.9 | 415.2 | 18.9 | 15.2 | 10.9 | 0.05 | 0.02 | 1.15 | 4.11 | 0.835 | 0.884 | 0.319 | 0.082 |
| BC | 8713.8 | 475.2 | 2.3 | 19.8 | 8713.8 | 475.2 | 2.3 | 19.8 | 0.98 | 0.58 | 0.17 | 7.47 | 0.355 | 0.471 | 0.692 | 0.029 |
| A2 | 14,021.1 | 14,466.2 | 180.5 | 84.8 | 14,021.1 | 14,466.2 | 180.5 | 84.8 | 1.58 | 17.64 | 13.66 | 32.00 | 0.249 | 0.004 | 0.008 | 0.001 |
| B2 | 32,249.5 | 620.5 | 4.2 | 0.5 | 32,249.5 | 620.5 | 4.2 | 0.5 | 3.63 | 0.76 | 0.32 | 0.18 | 0.098 | 0.413 | 0.591 | 0.683 |
| C2 | 23,800.1 | 5408.4 | 6.3 | 0.1 | 23,800.1 | 5408.4 | 6.3 | 0.1 | 2.68 | 6.60 | 0.48 | 0.06 | 0.146 | 0.037 | 0.512 | 0.820 |
| Residual | 62,123.6 | 5739.6 | 92.5 | 18.5 | 8874.8 | 819.9 | 13.2 | 2.6 | ||||||||
| Lack of Fit | 15,010.7 | 5584.1 | 74.4 | 6.0 | 5003.6 | 1861.4 | 24.8 | 2.0 | 0.42 | 47.86 | 5.49 | 0.64 | 0.746 | 0.001 | 0.067 | 0.627 |
| Pure Error | 47,112.9 | 155.6 | 18.1 | 12.5 | 11,778.2 | 38.9 | 4.5 | 3.1 | ||||||||
| Cor Total | 456,812.8 | 35,949.5 | 322.5 | 171.3 | ||||||||||||
| Solvent | Escherichia coli (10,000 c/mL) * | Pseudomonas sp. (15,000 c/mL) * | Micrococcus sp. (15,000 c/mL) * | ||||||
|---|---|---|---|---|---|---|---|---|---|
| Extracts Concentration (%) | |||||||||
| 2 | 1 | 0.5 | 2 | 1 | 0.5 | 2 | 1 | 0.5 | |
| Tar | 30 ± 6 | 100 ± 23 | 7400 ± 760 | 0 | 70 ± 9 | 100 ± 15 | 0 | 0 | 0 |
| CA | 30 ± 10 | 120 ± 31 | 6700 ± 920 | 0 | 0 | 0 | 0 | 0 | 0 |
| MA | 0 | 0.2 ± 0.009 | 4200 ± 230 | 0 | 0 | 0 | 0 | 0 | 0 |
| Mal | 0 | 0.15 ± 0.01 | 7000 ± 870 | 0 | 0 | 0 | 0 | 0 | 0 |
| Solvent | Extract Concentration (%) | |
|---|---|---|
| 50 | 2 | |
| Tar | 10,100 ± 1090 | 18,000 ± 2150 |
| CA | 5080 ± 890 | 19,500 ± 3060 |
| MA | 1000 ± 58 | 19,600 ± 2790 |
| Mal | 14,800 ± 1100 | 19,000 ± 3120 |
| Strain | Initial | Extract Concentration (%) | ||
|---|---|---|---|---|
| Number (c/mL) | 50 | 2 | 1 | |
| Escherichia coli | 10,000 ± 890 | 3500 ± 270 | 936 ± 60 | 9290 ± 1060 |
| Pseudomonas sp. | 25,000 ± 2150 | 15 ± 2 | 60 ± 5 | 130 ± 10 |
| Bacillus brevis | 15,000 ± 1050 | 14,600 ± 1500 | 14,800 ± 2800 | 13,700 ± 1200 |
| Micrococcus sp. | 20,000 ± 1870 | 85 ± 17 | 12,000 ± 2460 | 16,600 ± 1770 |
| Extract | Solvent | |
|---|---|---|
| Tar | 890 ± 60 | 10,280 ± 880 |
| CA | 210 ± 13 | 12,000 ± 1085 |
| MA | 0 | 30 ± 2 |
| Mal | 0 | 0 |
Disclaimer/Publisher’s Note: The statements, opinions and data contained in all publications are solely those of the individual author(s) and contributor(s) and not of MDPI and/or the editor(s). MDPI and/or the editor(s) disclaim responsibility for any injury to people or property resulting from any ideas, methods, instructions or products referred to in the content. |
© 2023 by the authors. Licensee MDPI, Basel, Switzerland. This article is an open access article distributed under the terms and conditions of the Creative Commons Attribution (CC BY) license (https://creativecommons.org/licenses/by/4.0/).
Share and Cite
Tsvetov, N.; Paukshta, O.; Fokina, N.; Volodina, N.; Samarov, A. Application of Natural Deep Eutectic Solvents for Extraction of Bioactive Components from Rhodiola rosea (L.). Molecules 2023, 28, 912. https://doi.org/10.3390/molecules28020912
Tsvetov N, Paukshta O, Fokina N, Volodina N, Samarov A. Application of Natural Deep Eutectic Solvents for Extraction of Bioactive Components from Rhodiola rosea (L.). Molecules. 2023; 28(2):912. https://doi.org/10.3390/molecules28020912
Chicago/Turabian StyleTsvetov, Nikita, Oksana Paukshta, Nadezhda Fokina, Natalia Volodina, and Artemiy Samarov. 2023. "Application of Natural Deep Eutectic Solvents for Extraction of Bioactive Components from Rhodiola rosea (L.)" Molecules 28, no. 2: 912. https://doi.org/10.3390/molecules28020912
APA StyleTsvetov, N., Paukshta, O., Fokina, N., Volodina, N., & Samarov, A. (2023). Application of Natural Deep Eutectic Solvents for Extraction of Bioactive Components from Rhodiola rosea (L.). Molecules, 28(2), 912. https://doi.org/10.3390/molecules28020912

